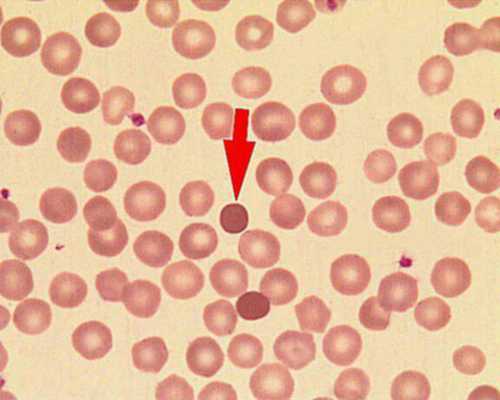
Сфероциты

Тест на осмотическую резистентность эритроцитов - методика, показатели нормы
Добавил пользователь Валентин П. Обновлено: 12.12.2025
Резистентность - свойство эритроцитов противостоять разрушительным воздействиям: тепловым, осмотическим, механическим и др. В клинике наибольшее значение приобрело определение осмотической резистентности.
Принцип метода состоит в том, что эритроциты в гипертонических солевых растворах сморщиваются, а в гипотонических - набухают. При значительном набухании наступает гемолиз.
В пробирках готовят растворы хлорида натрия различной концентрации (от 0.70 до 0.22%), затем вносят в них один и тот же объем крови (0.02 мл) и оставляют на час при комнатной температуре. Через час пробирки центрифугируют и определяют начало гемолиза по легкому порозовению раствора и полный гемолиз - по интенсивной красно-лаковой окраске раствора.
В норме минимальная резистентность у взрослых людей колеблется между 0,48% и 0,46% хлорида натрия, максимальная - между 0,34% и 0,32% хлорида натрия.
Снижение осмотической резистентности эритроцитов наблюдается при наследственном микросфероцитозе (болезнь Минковского-Шоффара), аутоиммунных гемолитических анемиях. Повышение осмотической резистентности эритроцитов встречается при наследственных гемолитических анемиях, связанных с дефицитом глюкозо-6-фосфатдегидрогеназы, при некоторых гемоглобинопатиях (талассемия).
Измерение диаметра эритроцитов и графическую регистрацию распределения эритроцитов по величине (эритроцитометрическая кривая Прайс-Джонса) производят с помощью прямых микроскопических и электронно-автоматических методов.
Прямой микроскопический метод - это измерение диаметра эритроцитов в фиксированном и окрашенном мазке крови с использованием окуляр - микрометра и объектив-микрометра. Измеряют диаметр 200-500 различных эритроцитов, результаты распределяют по группам в зависимости от величины диаметра и устанавливают в процентах (%) относительную численность каждой группы.
Нормы: содержание нормоцитов (диаметр 6.9-8.0 мкм) составляет приблизительно 68%, микроцитов (диаметр менее 6.9 мкм) - 15%, макроцитов (диаметр более 8.0 мкм) - 17%.
Прямой микроскопический метод чрезвычайно трудоемок, отнимает много времени и поэтому уступает электронно-автоматическому методу.
Электронно-автоматический метод - это подсчет эритроцитов различного диаметра с помощью счетчиков «Культер» и «Целлоскоп».
Эритроцитометрическая кривая Прайс-Джонса в норме имеет правильную форму с вершиной на 7.2 мкм и довольно узким основанием в пределах 6-9 мкм.
Увеличение диаметра эритроцитов (макроцитоз) со сдвигом кривой Прайс - Джонса вправо наблюдается при мегалоцитарных анемиях (витамин-В12-фолиеводефицитные), при заболеваниях печени, при алкоголизме.
Уменьшение диаметра эритроцитов (микроцитоз) со сдвигом эритроцитометрической кривой влево встречается при наследственном микросфероцитозе, железодефицитной анемии, интоксикации свинцом.
Нормальные эритроциты имеют форму диска с вдавлением в центре. В патологических случаях могут появляться эритроциты с измененной формой. Изменение формы эритроцитов называется пойкилоцитозом. Встречаются следующие формы эритроцитов.
Сфероциты - эритроциты, имеющие округлый или шарообразный вид, утратившие двояковогнутую форму. Микросфероциты имеют иногда обычные размеры. Сфероцитоз бывает наследственным и приобретенным. Наблюдается при наследственном микросфероцитозе (болезнь Минковского-Шоффара), гемолитических анемиях, сепсисе, искусственных клапанах сердца.
Овалоциты (эллиптоциты) - эритроциты овальной формы. Встречаются при талассемии, наследственном овалоцитозе, тяжелых железодефицитных анемиях, анемиях при лейкозах.
Мишеневидные эритроциты (таргентные клетки, лептоциты) - плоские, бледные, с центральным скоплением гемоглобина в виде мишеней. Бывают при талассемии, тяжелых железодефицитных анемиях, после спленэктомии, при различных видах желтух, алкоголизме. Стоматоциты — центральное просветление у таких эритроцитов изогнуто, напоминает форму рта. Встречаются при наследственных стоматоцитозах (относятся к гемолитическим анемиям), после переливания крови, при опухолях и циррозе печени, остром алкогольном отравлении.
Акантоциты - эритроциты зазубренной формы, имеющие выпячивания различной величины. Обнаруживаются при наследственных акантоцитозах, тяжелых заболеваниях печени (токсических гепатитах, циррозах), гипотиреозе, терапии гепарином, хроническом алкоголизме, после спленэктомии.
Эхиноциты - эритроциты с несколькими выростами, как бы покрытые шипами, колючками. Такие формы наблюдаются при тромбоцитопенической пурпуре, раке желудка, уремии. Если в мазке все эритроциты имеют такую форму, это говорит о неправильной фиксации мазка.
Каплевидные эритроциты имеют форму капель. Встречаются при миелофиброзе и токсических гепатитах.
Анулоциты - эритроциты в виде пустых колец. Наблюдаются в периферической крови при тяжелых формах железодефицитных анемий.
Серповидные эритроциты (дрепаноциты) имеют форму серпов, полулуний, овсяных зерен. Образуются в крови при серповидно-клеточной анемии.
В отличии от анизоцитоза, пойкилоцитоз является более поздним признаком анемии и отмечается при более тяжелом течении.
В норме зрелые эритроциты периферической крови не содержат никаких включений. И только в ретикулоцитах при суправитальной окраске красителем бриллиант-крезил-блау выявляется зернистосетчатая субстанция.
При различных патологических состояниях в периферической крови обнаруживаются эритроциты с различными включениями: базофильная пунктация — мелкая, синего цвета, равномерно расположенная в цитоплазме зернистость, встречается при отравлении свинцом, ртутью и нередко при некоторых анемиях (мегалобластные, талассемия и др.); крапчатость Шуффнера - мелкая красного цвета зернистость, отмечается при трехдневной малярии; пятнистость Маурера - небольшие сиреневого или красного цвета пятнышки, встречаются при тропической малярии; тельца Гейнтца-Эрлиха - круглые резко очерченные включения по периферии эритроцита, появляются при отравлении гемолитическими ядами типа нитробензола, анилина, фенилгидразина, при лучевой болезни; тельца Жолли - круглые, сине-фиолетового цвета образования; кольца Кебота - нежные петельки красного цвета. Они имеют вид колечка, восьмерки или скрипичного ключа. Тельца Жолли представляют собой остатки ядерной субстанции нормобластов, а кольца Кебота - остатки ядерной оболочки и встречаются главным образом при витамин-В12- и фолиеводефицитной анемии, тяжелых отравлениях гемолитическими ядами.
Помимо телец Жолли и колец Кебота при витамин-В12- и фолиеводефицитной анемии в периферической крови можно увидеть клеточные элементы мегалобластического типа кроветворения, который в норме отмечается только в эмбриональном периоде.
При мегалобластическом кроветворении в кроветворной ткани вместо эритробластов образуются мегалобласты, которые способны к ранней гемоглобинизации при сохранившейся еще структуре ядра. По сродству к щелочным или кислым красителям они подразделяются на базофильные, оксифильные и полихроматофильные. Большая их часть распадается в костном мозге, а меньшая - созревает до мегалоцитов, которые и поступают в периферическую кровь. При резком обострении заболевания в периферическую кровь попадают не только мегалоциты, но и мегалобласты. Мегалобласт представляет собой крупную клетку (диаметром более 15 мкм) с эксцентрично расположенным круглым или овальным ядром. Мегалоциты - это безъядерные клетки размером от 12 до 15 мкм, значительно насыщенные гемоглобином. Поэтому цветной показатель, как правило, при В12- и фолиево-дефицитной анемии больше 1,0 (эту разновидность анемии относят к гиперхромным).
Оседание эритроцитов - это свойство клеток крови осаждаться (седементировать) за пределами кровеносного русла (на дне сосуда при сохранении крови в несвертывающемся состоянии), оставляя сверху слой плазмы. Этот феномен лежит в основе определения скорости оседания эритроцитов (СОЭ), которая выражается в миллиметрах плазмы, отстаивающейся в течение часа.
Наиболее распространен микрометод определения СОЭ в модификации Панченкова.
Принцип метода: при стоянии крови, стабилизированной цитратом натрия, эритроциты оседают с различной скоростью в зависимости от физико-химических свойств крови. Скорость оседания эритроцитов (СОЭ) выражается в мм/ч.
Оборудование и реактивы:
аппарат Панченкова, состоящий из штатива с капиллярами шириной 1 мм, на стенке которых нанесены деления от 0 (сверху) до 100 (снизу). На уровне 0 мм имеется буква К (кровь), а на середине капилляра, около метки 50 мм - буква Р (реактив);
агглютационные (видалевские пробирки);
5% свежеприготовленный раствор натрия цитрата;
Ход исследования. В капилляр Панченкова набирают 5% раствор натрия цитрата до метки «Р» - 50 мм и выдувают его в видалевскую пробирку. Затем этим же капилляром, держа его горизонтально, из уколотого пальца набирают два раза кровь до метки «К» - 0 мм и выпускают ее в пробирку с натрия цитратом. Хорошо перемешивают. Этим же капилляром набирают цитратную кровь до метки «К» и ставят строго вертикально в штатив. Полученное соотношение объемов крови и натрия цитрата равно 1:4. Через 1 ч отмечают по делениям на капилляре число миллиметров освободившегося от эритроцитов столбика плазмы.
Интерпретация полученных данных. Нормальные показатели СОЭ:
у мужчин - СОЭ 1-10 мм/ч;
у женщин - СОЭ 2-15 мм/ч
Дети имеют более низкую СОЭ (1-8 мм/ч), чем взрослые, а лица среднего возраста меньше, чем старики.
Изменение СОЭ при патологии.
Значительное увеличение - опухолевые заболевания, диффузные болезни соединительной ткани, тяжелые инфекции, болезни почек, протекающие с нефротическим синдромом, выраженная витамин-В12-фолиеводефицитная анемия.
Умеренное увеличение - острые и хронические инфекционные заболевания, локализированные гнойные процессы, инфаркт миокарда, гипертиреоз, тяжелый сахарный диабет, внутренние кровотечения, интоксикации ртутью и мышьяком.
Снижение - эритремия, вторичные симптоматические эритроцитозы, ацидоз, тяжелая сердечная недостаточность.
Определение осмотической резистентности эритроцитов (Osmotic fragility (OF) test, RBC)
Синонимы: Анализ крови на осмотическую резистентность эритроцитов; Осмотическая резистентность эритроцитов (ОРЭ); Осмотическая стойкость эритроцитов.
Osmotic fragility test (OFT); Osmotic fragility of red blood cells; Red blood cell osmotic fragility test.
Краткая характеристика теста на Осмотическую резистентность эритроцитов
Тест на осмотическую резистентность эритроцитов заключается в измерении их устойчивости к гемолизу при воздействии солевых растворов разной концентрации. Когда эритроциты попадают в гипотоническую среду, вода по осмотическому градиенту устремляется в клетки, что может приводить к разрушению и лизису (гемолизу) эритроцитов. Осмотическая устойчивость характеризует способность эритроцитов принимать воду без лизиса клетки, она зависит, в частности, от соотношения площади поверхности к объему клетки.
С какой целью исследуют Осмотическую резистентность эритроцитов
Оценка осмотической резистентности эритроцитов - классический тест, используемый в диагностике наследственного сфероцитоза. Наследственный сфероцитоз - гетерогенная группа наследственных гемолитических анемий, развивающихся вследствие генетических дефектов, которые приводят к дефекту или дисфункции белков мембраны и цитоскелета эритроцитов, в результате чего эритроциты приобретают характерную сферическую форму. Это приводят к ускоренному разрушению эритроцитов в селезенке и укорочению их срока жизни. Сфероциты являются осмотически менее стойкими клетками, которые легче лизируются в гипотоническом растворе, по сравнению с нормальными эритроцитами. Заболевание проявляется гемолитической анемией различной степени выраженности, спленомегалией, желтухой. В крови наблюдается обычно микроцитарная нормохромная анемия, ретикулоцитоз. Гемолитические кризы могут возникать при инфекциях или интоксикациях. Другим частным осложнением субклинического сфероцитоза является желчнокаменная болезнь, возникающая в раннем возрасте, которая может быть одним из показаний для обследования пациентов. Нормальная осмотическая резистентность эритроцитов не исключает диагноз наследственного сфероцитоза и может отмечаться у 10-20% таких пациентов, осмотическая стойкость может быть нормальной при сочетании с дефицитом железа, обтурационной желтухой, в фазе восстановления после апластического криза (когда увеличено число ретикулоцитов).
Напротив, повышенная осмотическая стойкость эритроцитов указывает на наличие сплющенных эритроцитов (лептоцитов), в таких клетках снижено соотношение площади поверхности к объему. Подобные изменения наблюдаются при железодефицитной анемии, талассемии и серповидноклеточной анемии, так как эритроциты с низким содержанием гемоглобина (эритроцитарный индекс MCH) и низким средним объемом клеток (эритроцитарный индекс MCV) необычайно устойчивы к осмотическому лизису.
Что может повлиять на результат оценки Осмотической резистентности эритроцитов
Осмотически более устойчивы ретикулоциты и эритроциты у пациентов после спленэктомии. При заболеваниях печени, вследствие пассивного накопления липидов, эритроциты также проявляют относительно большую резистентность к осмотическому лизису.
Правила подготовки к Определению осмотической резистентности эритроцитов
Специальной подготовки не требуется. Рекомендуется проводить взятие крови не ранее, чем через 4 часа после последнего приема пищи.
В каких случаях проводят Определение осмотической резистентности эритроцитов:
- дифференциальная диагностика гемолитических анемий;
- подтверждение наследственного сфероцитоза;
- желчнокаменная болезнь в раннем возрасте;
- гиперспленизм и спленомегалия.
Интерпретация результатов исследований содержит информацию для лечащего врача и не является диагнозом. Информацию из этого раздела нельзя использовать для самодиагностики и самолечения. Точный диагноз ставит врач, используя как результаты данного обследования, так и нужную информацию из других источников: анамнеза, результатов других обследований и т.д.
Осмотическая резистентность эритроцитов
Под резистентностью эритроцитов понимают их устойчивость к различным разрушающим факторам: механическим, тепловым и другим. Особое значение в лабораторных исследованиях имеет осмотическая резистентность эритроцитов, то есть устойчивость к гипотоническим растворам NaCl разной концентрации. С помощью специального теста определяют, при какой концентрации хлорида натрия начинается распад красных кровяных телец (гемолиз).
Эритроциты для нормального функционирования должны сопротивляться осмотическому давлению, то есть должны быть прочными. Способность к сопротивлению и называется осмотической устойчивостью, или резистентностью. Если красные тельца становятся слабыми, иммунная система их маркирует как отработанный материал и удаляет из организма.
Выделяют резистентность максимальную и минимальную. Максимальная соответствует концентрации гипотонического раствора NaCl, при которой в течение 3-х часов происходит гемолиз всех красных клеток. Минимальная определятся концентрацией раствора, при которой разрушаются наименее устойчивые эритроциты.
Что такое физраствор?
Физраствор - это дистиллированная вода с растворенной в ней поваренной солью. Физиологический раствор с концентрацией 0,85 процентов называют изотоническим. В нем разрушения эритроцитов не происходит.

Если концентрация соли ниже, раствор называют гипотоническим, если выше - гипертоническим. При помещении в такие растворы эритроциты начинают разрушаться. В гипертоническом, или гиперосмотическом, они теряют воду и сморщиваются. В гипотоническом, или гипоосмотическом, они поглощают воду и набухают.
Как проводится анализ?
Чтобы провести пробы на осмотическую резистентность эритроцитов, в пробирки помещают гипотонический раствор NaCl разной концентрации (от 0,7 % до 0,22%). В каждую пробирку добавляют одинаковое количество крови, как правило - 0, 02 мл. В течение часа держат при комнатной температуре, после чего центрифугируют и по цвету раствора определяют начало разрушения эритроцитов и полный гемолиз. Если раствор слегка порозовел, это говорит о начале разрушения. При полном распаде раствор приобретает ярко-красный цвет.
В результате получают два параметра - максимальную и минимальную резистентность, которая выражается в процентах.
Норма
Для взрослых людей нормой считается:
- максимальная резистентность - от 0,34% до 0,32%;
- минимальная - от 0,48% до 0,46%.
У детей до двух лет осмотическая устойчивость в норме выше, чем у более старших. У пожилых людей - немного ниже нормы.
Причины отклонения от нормы
Причин отклонения от нормы много. Максимальная резистентность (ниже 0,32%) наблюдается при:
- талассемии;
- некоторых случаях полицитемии;
- гемоглобинопатии;
- спленэктомии;
- массивных кровотечениях;
- застойной желтухе;
- гемоглобинозе;
- атеросклерозе;
- злокачественных опухолях ЖКТ.

Поведение эритроцитов в гипертоническом, изотоническом и гипотоническом растворе
Минимальная осмотическая стойкость (выше 0,48%) связана:
- с гемолитической анемией новорожденных;
- с отравлением свинцом;
- с гемолитической анемией наследственной.
Незначительное снижение может происходить при следующих состояниях:
- туберкулезе;
- лейкозе;
- циррозе печени;
- некоторых случаях полицитемии.
К причинам снижения осмотической резистентности также можно отнести:
- присутствие в крови шарообразных эритроцитов, что обусловлено генетически;
- сердечную недостаточность, при которой красные клетки набухают, принимают сферическую форму, что сокращает их продолжительность жизни;
- старение эритроцитов, завершающий этап их жизни, во время которого они приобретают шарообразную форму, при этом проницаемость их стенок значительно увеличивается.
Признаки нарушения осмотической устойчивости
Симптомы такого отклонения бывают следующими:
- повышение температуры тела, иногда до высоких значений;
- быстрая утомляемость;
- плохой аппетит;
- общая слабость;
- бледность слизистых оболочек;
- снижение веса;
- сонливость.
Сфероциты (шарообразные эритроциты) менее устойчивы к осмотическому давлению
Зависимость резистентности от формы и зрелости эритроцита
Осмотическая стойкость зависит от формы и возраста клеток. В норме эритроциты имеют невысокий индекс сферичности, но в крови могут присутствовать элементы шарообразной формы, которые отличаются более низкой устойчивостью к разрушению. При такой форме значительно снижается резистентность, которая в этом случае составляет 0,4-0,6 % при норме 0,32-0,44. Сферическая форма может быть наследственно обусловлена. Кроме того, она наблюдается у клеток, которые завершают свой жизненный цикл.
Вывод
Таким образом, можно сделать вывод о том, что более резистентные - это молодые красные тельца, появляющиеся в крови после выхода из костного мозга и имеющие небольшой индекс сферичности.
Читайте также:
- Техника латерального доступа к бедренной кости
- Хорионический гонадотропин человека (ХГЧ). Функции хорионического гонадотропина человека
- Скорость диффузии. Закон Фика. Принципы облегченной диффузии.
- Случай успешного лечения критического стеноза сонной артерии на фоне перенесенного ишемического инсульта
- Синдром Прасада-Коуза (Prasad-Koza)
